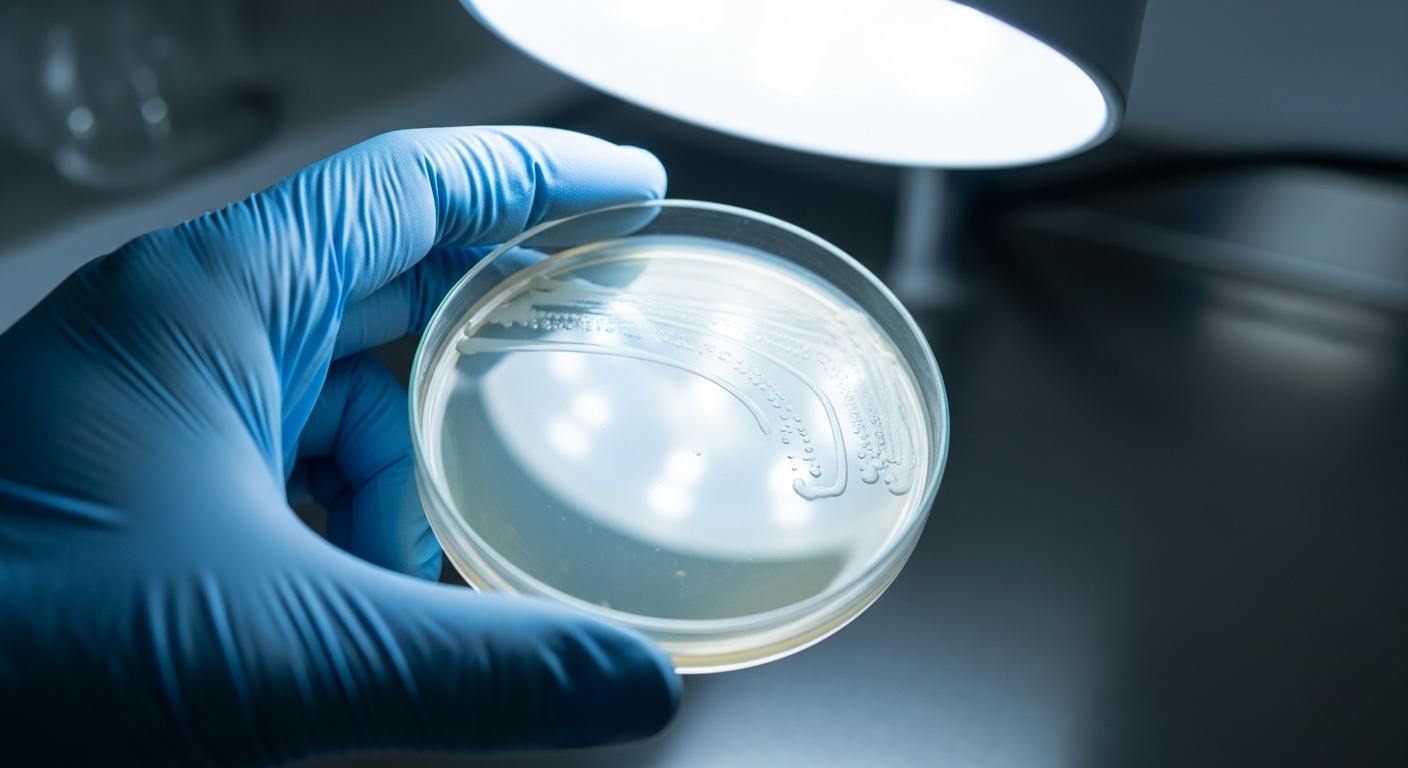

Préparez-vous à un hiver infesté de vomissements : le norovirus fait son grand retour !
Auteur: Simon Kabbaj
L’hiver et ses microbes sont de retour

Quand l’hiver pointe le bout de son nez, on pense tout de suite au rhume et à la grippe. Mais il y a un autre invité indésirable qui s’installe discrètement : le norovirus. Vous le connaissez peut-être mieux sous le nom de « gastro-entérite » ou « grippe intestinale ». Et cette année, il semblerait qu’il soit bien décidé à nous compliquer la vie.
Alors, mieux vaut être prévenu et préparer ses défenses. Personne n’a envie de passer les fêtes au fond de son lit, n’est-ce pas ?
Les chiffres parlent d’eux-mêmes
Les nouvelles qui nous viennent des États-Unis ne sont pas très rassurantes. Les Centres de contrôle et de prévention des maladies (le fameux CDC) ont tiré la sonnette d’alarme. Les cas de norovirus sont en train de grimper en flèche.
Pour vous donner une idée, la semaine dernière, environ 14% des tests de laboratoire sont revenus positifs pour le norovirus. C’est le double d’il y a trois mois ! C’est un signe qui ne trompe pas : le virus circule beaucoup en ce moment.
Un hiver qui s’annonce difficile ?
On dirait bien que l’on se dirige vers un hiver compliqué, un peu comme l’année dernière. Le taux de tests positifs de mi-novembre est quasiment le même que celui de l’an passé à la même période. Et si on se souvient bien, en décembre 2024, il y a eu une vague record de cas de gastro, avec un pic de près de 25% de tests positifs. On espère ne pas revivre ça…
Certains États américains, comme le Wyoming, le Nebraska et l’Oklahoma, sont déjà particulièrement touchés. Cela nous montre que la vigilance est de mise partout, car ce virus voyage très, très vite.
Ce n’est pas une simple « gastro »

On a tendance à banaliser la gastro, mais il ne faut pas la prendre à la légère. Chaque année, le norovirus est responsable d’environ 20 millions de cas de vomissements et de diarrhées rien qu’aux États-Unis. C’est énorme.
Même si la maladie est rarement mortelle, elle peut être très affaiblissante, surtout pour les personnes fragiles. Elle conduit tout de même près de 100 000 Américains à l’hôpital chaque année. Il faut donc être particulièrement prudent.
Les bons gestes pour se protéger efficacement

Alors, que faire pour passer entre les mailles du filet ? Heureusement, il y a des gestes simples mais très efficaces. La première règle, et la plus importante, c’est l’hygiène.
Lavez-vous les mains très souvent avec du savon et de l’eau. J’insiste sur ce point : le gel hydroalcoolique ne fonctionne pas contre le norovirus. C’est le lavage méticuleux qui compte.
En cuisine, la prudence est aussi de mise. Lavez bien les fruits et les légumes. Faites bien cuire les coquillages. Nettoyez vos ustensiles, planches à découper et surfaces de travail, surtout après avoir préparé des fruits de mer crus. Et si jamais vous vous sentez un peu nauséeux, évitez le contact avec vos proches et redoublez de vigilance sur le lavage des mains.
Conclusion : Un peu de prudence pour des fêtes sereines
Avec les repas de famille et les fêtes de fin d’année qui approchent, c’est encore plus important d’être prudent. On a tous envie de profiter de nos proches en bonne santé. Ça demande un petit effort, c’est vrai, mais ça en vaut vraiment la peine.
Personne n’a envie d’une mauvaise surprise digestive pour Noël. Alors, un bon lavage de mains, une cuisine propre, et on met toutes les chances de son côté pour passer un hiver tranquille. En attendant, comme beaucoup, j’espère que les scientifiques nous trouveront bientôt un vaccin efficace contre ce virus tenace !
Ce contenu a été créé avec l’aide de l’IA.